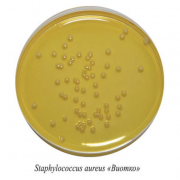
Стафилококкагар Стафилококкагар

ГК «ПанЭко» поздравляет с Днем России!
10 Июня 2026, Ср
Группа компаний «ПанЭко» поздравляет вас с Днем России!
ГК «ПанЭко» приняла участие в юбилейной конференции ВИЛАР
05 Июня 2026, Пт
ГК «ПанЭко» приняла участие в юбилейной конференции ВИЛАР, посвященной 95-летию института.
ГК «ПанЭко» поздравляет с Днем защиты детей!
01 Июня 2026, Пн
Сегодня 1 июня – день, который напоминает о необходимости заботы о самых беззащитных, детях.
Продукция для культивирования за полцены – ограниченное предложение на питательные среды и реактивы!
29 Мая 2026, Пт
Уважаемые клиенты и партнеры! Предлагаем приобрести высококачественные питательные среды и реактивы со скидкой 50%.